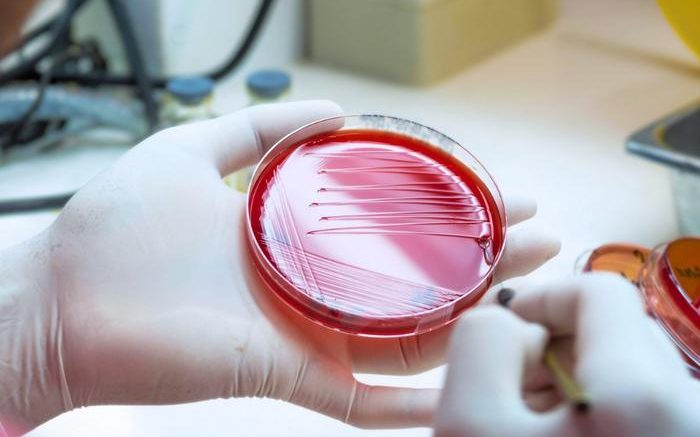

An under-recognized strep bacterium is causing a growing number of serious infections in Australia, with First Nations Australians disproportionately affected, according to new research published today in The Lancet Microbe.
The study, led by the Peter Doherty Institute for Infection and Immunity (Doherty Institute), examined invasive infections caused by Streptococcus dysgalactiae subspecies equisimilis (SDSE), a close cousin to Streptococcus pyogenes (group A strep or Strep A). Like group A strep, SDSE can cause skin and soft tissue infections and, in severe cases, invade the blood and organs, leading to life-threatening illness.
For the first time, researchers measured the burden of invasive SDSE infections across Australia, comparing trends in southeast Australia and the Northern Territory’s Top End. The team analyzed more than a decade of clinical and genomic data from hospitals across the regions. Building on earlier research into group A strep, they compared the incidence, demographics and outcomes of invasive SDSE (iSDSE) infections with those of invasive group A strep (iGAS), uncovering important differences in how the two pathogens spread and who they affect.
The University of Melbourne’s Dr. Ouli Xie, clinician researcher in the Davies-Tong Laboratory at the Doherty Institute and first author of the paper, said the study revealed rising rates of infection and disparities between regions.
“We found that, in urban areas in southeast Australia, iSDSE infections occurred at a similar rate to iGAS and have steadily increased between 2011 and early 2023. In remote northern regions, iSDSE was less common than iGAS, but the number of cases was still 25 per cent higher than in southeast Australia,” said Xie.
“For years SDSE has been seen as a minor player compared to group A strep, but our study shows it is causing a significant and rising burden of severe disease in Australia, predominantly in older Australians.”
The University of Melbourne’s associate professor Mark Davies, laboratory head at the Doherty Institute and co-lead author, said genomic analysis of patient samples uncovered important insights.
“Genome sequencing revealed that, although SDSE and group A strep are closely related, they behave differently in terms of transmission and recurrence, and they affect populations differently,” said Davies.
“This suggests that control strategies used for iGAS, like giving antibiotics to close contacts, may not work as well for iSDSE.”
The team also found that more than one in four cases were linked to stG62647, a bacterial clone of SDSE rapidly spreading in Europe and North America, and now in Australia.
The Royal Melbourne Hospital’s Professor Steven Tong, Group Head and Clinician Researcher at the Doherty Institute and co-lead author, said the findings shed light on health inequities faced by First Nations Australians in remote regions.
“Within the Top End itself, which already had higher rates of iSDSE than southeast Australia, First Nations Australians were further disproportionately affected, experiencing more than three times the risk of invasive disease compared with non-First Nations individuals,” said Tong.
“We urgently need strategies that address the social determinants of health driving this burden, as well as new approaches to prevent and treat invasive strep infections.”
Together with the team’s earlier iGAS research (The Lancet Microbe, June 2025, 10.1016/j.lanmic.2024.101053), the findings provide the most comprehensive picture to date of invasive streptococcal disease in Australia. They highlight the urgent need for improved surveillance, prevention in vulnerable communities and exploration of vaccines or therapeutics, with industry partners such as Moderna already expressing interest in the genomic data with the goal of developing a vaccine that might work across both SDSE and group A strep.
This work is a result of a collaboration led by the Doherty Institute with Monash Health, Menzies School of Health Research, University of Technology Sydney, Royal Darwin Hospital, Blacktown Hospital, Westmead Hospital, Northern Territory Department of Health and Monash University.
Reference: Xie O, et al. Invasive Streptococcus dysgalactiae subspecies equismilis compares with Streptococcus pyogenes in Australia, 2011-23, and the emergence of a multi continent stG62647 lineage; a retrospective clinical and genomic epidemiology study. The Lancet Microbe (2025). DOI: http://www.doi.org/10.1016/j.lanmic.2025.101182
Source: Doherty Institute